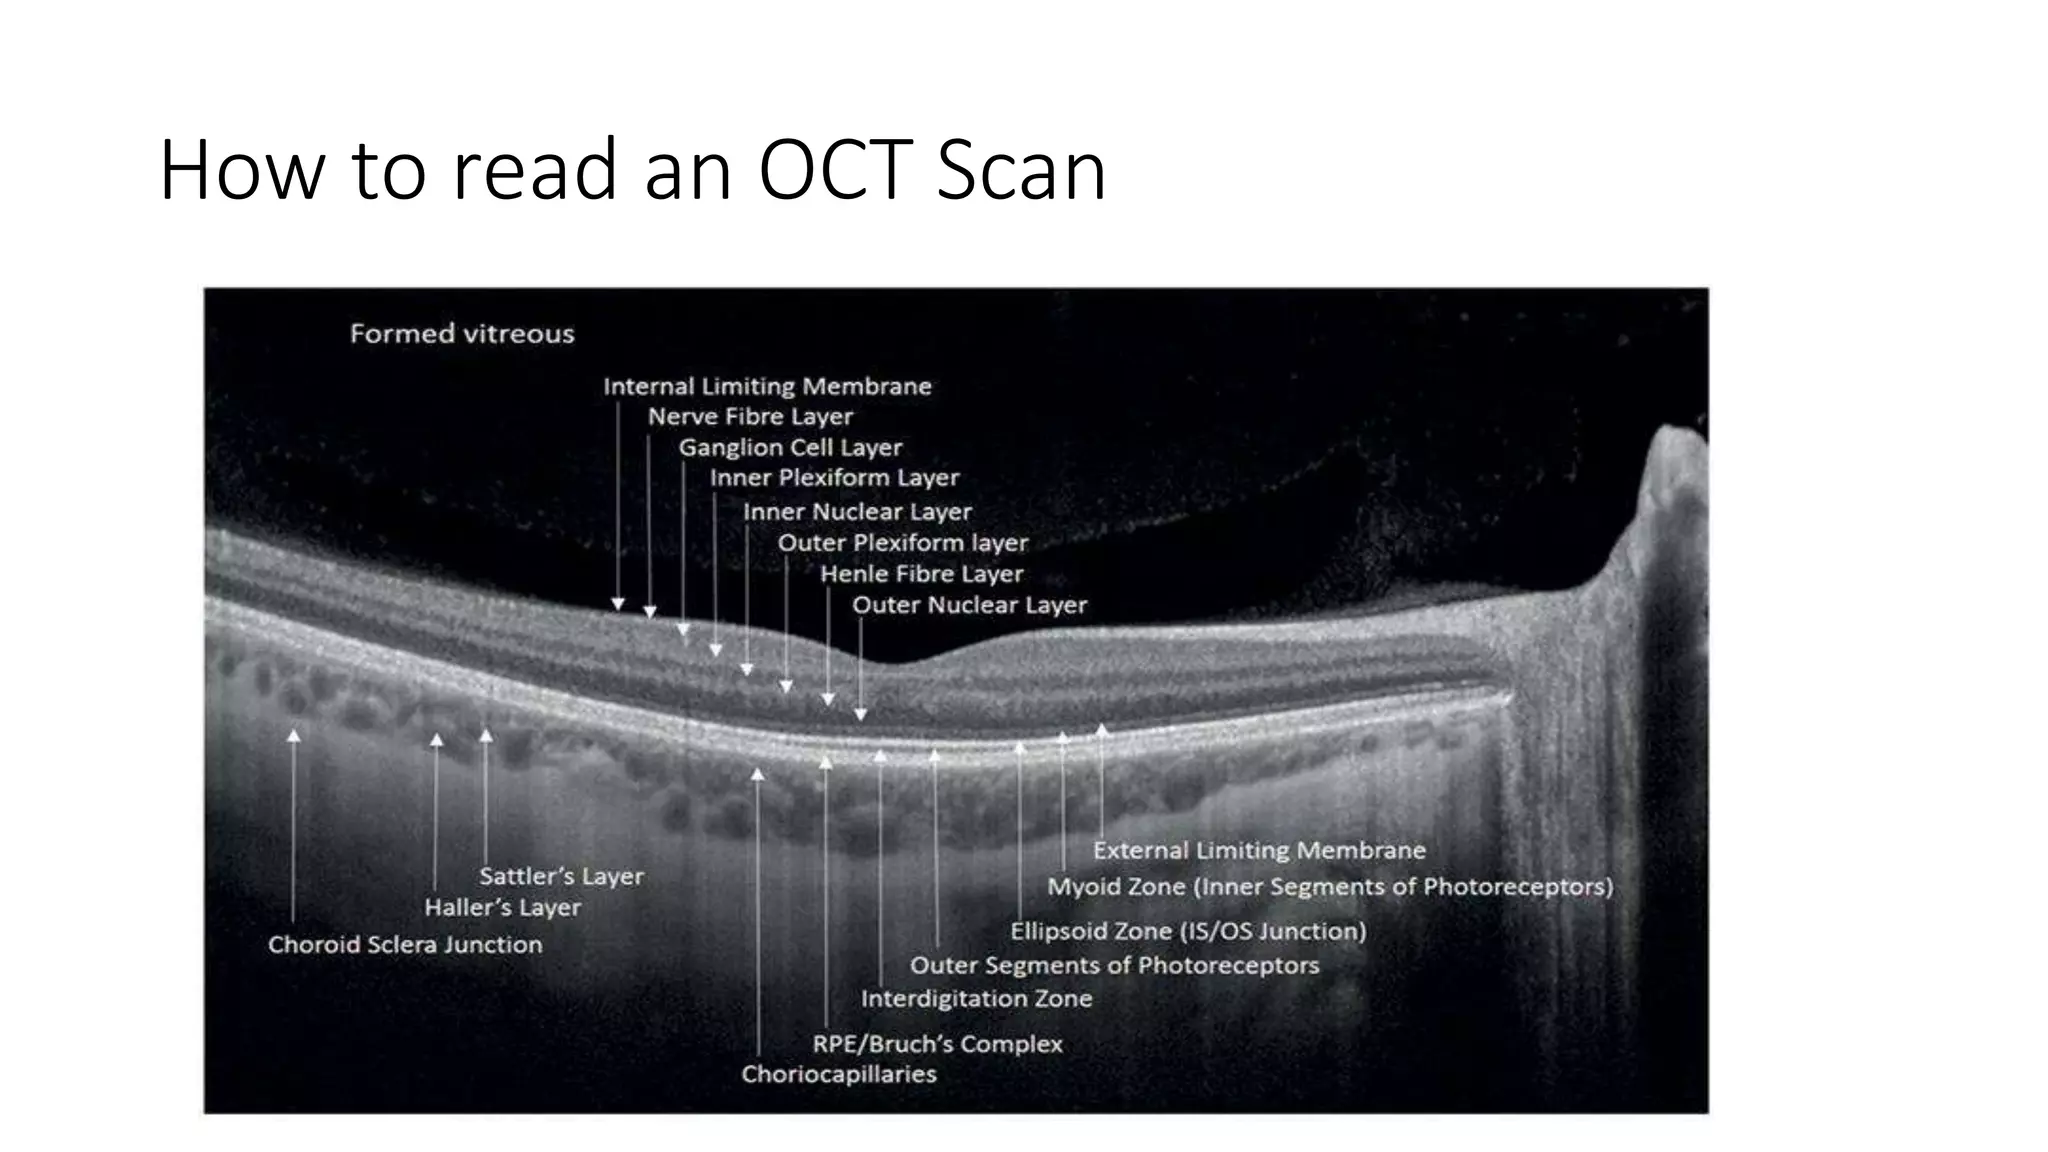
How to read an OCT Scan
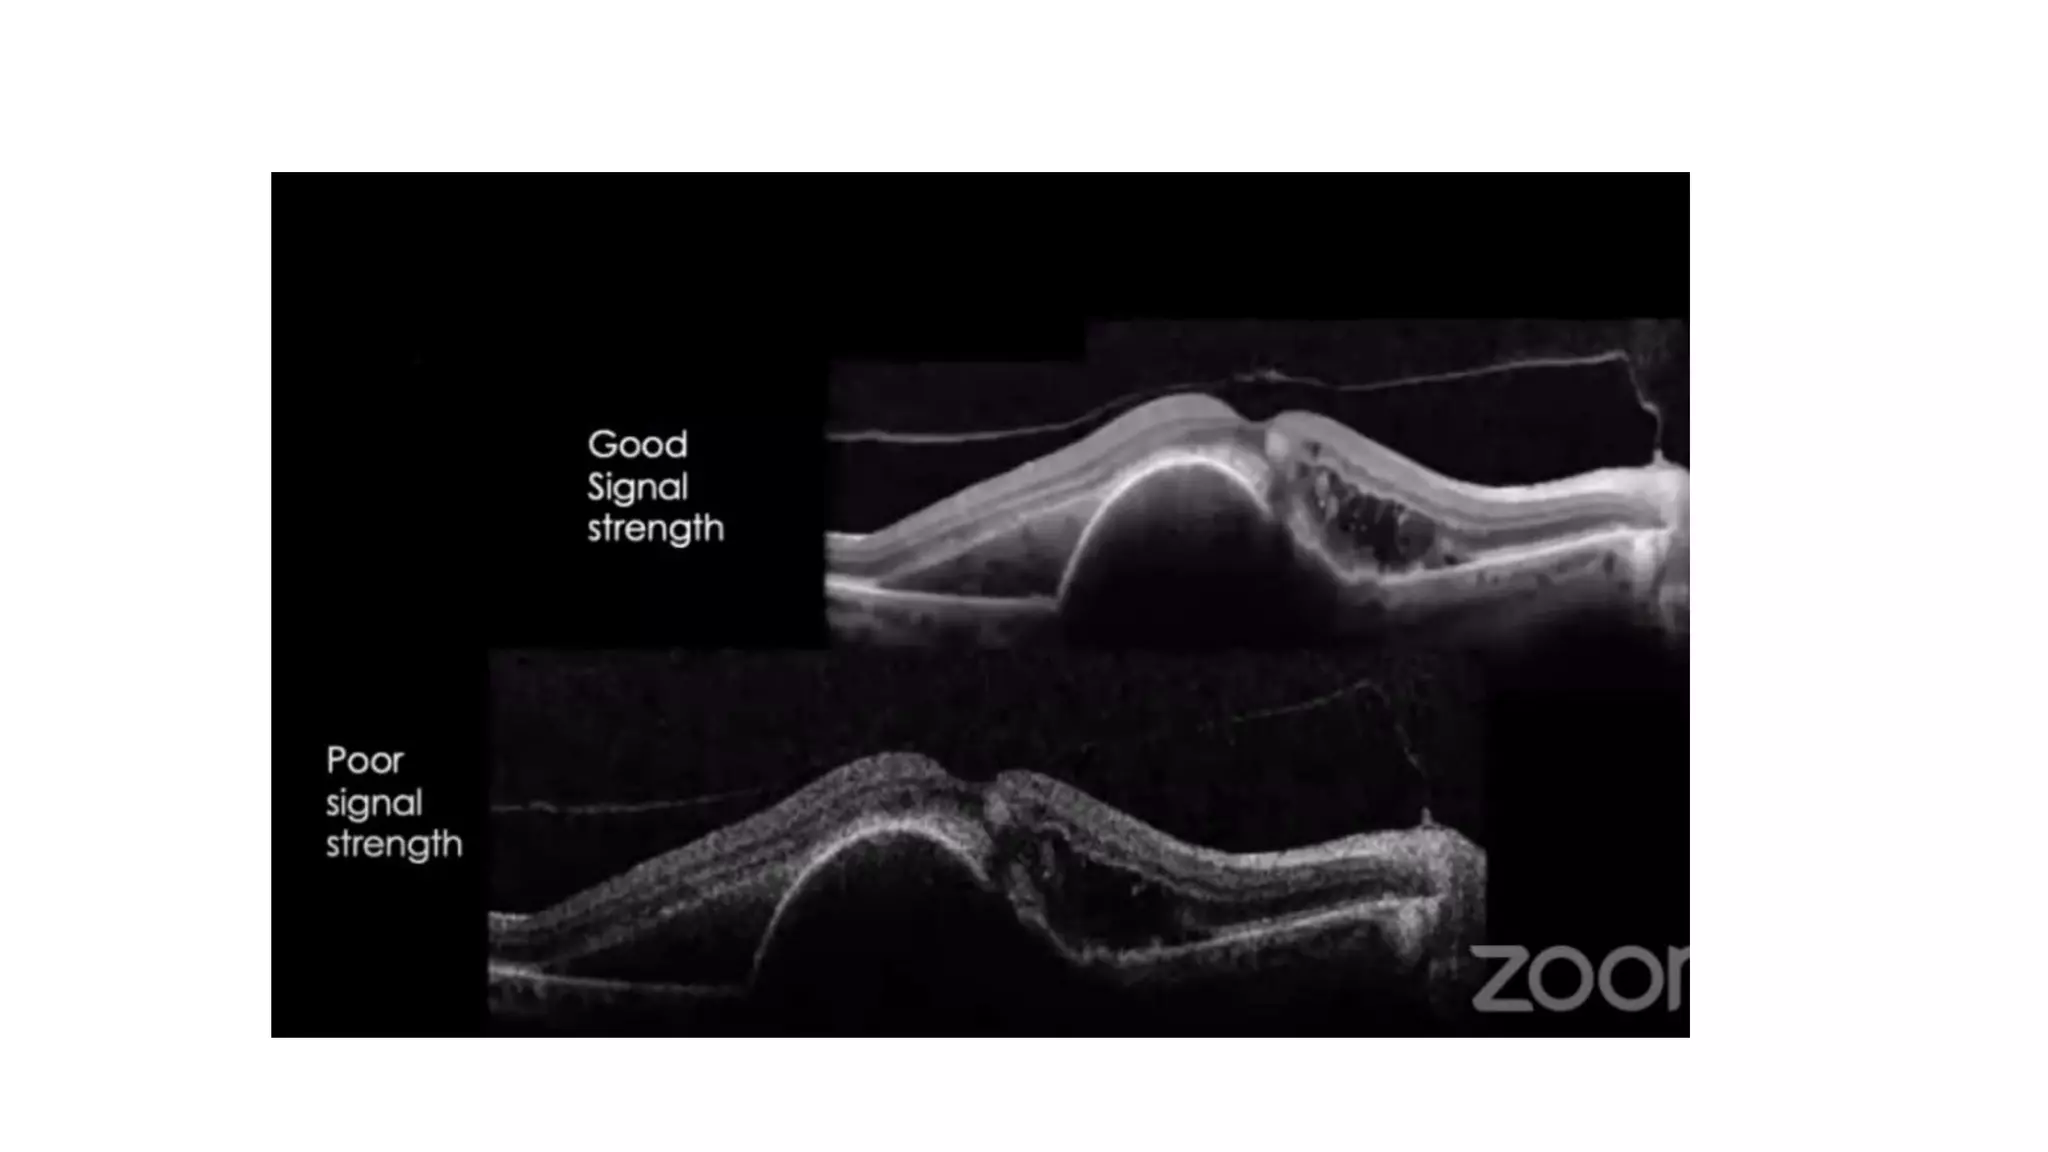

OCT provides high resolution cross-sectional images of the retina. It works by comparing the echo time delay of light reflected from retinal structures to a reference mirror. There are different OCT protocols that image the retina in various ways. When reading an OCT scan, clinicians examine the layer structure, reflectivity, and thickness to identify normal features and pathologies. Common retinal conditions like diabetic macular edema, retinal vein occlusions, and age-related macular degeneration have characteristic OCT findings that aid in diagnosis and monitoring treatment.